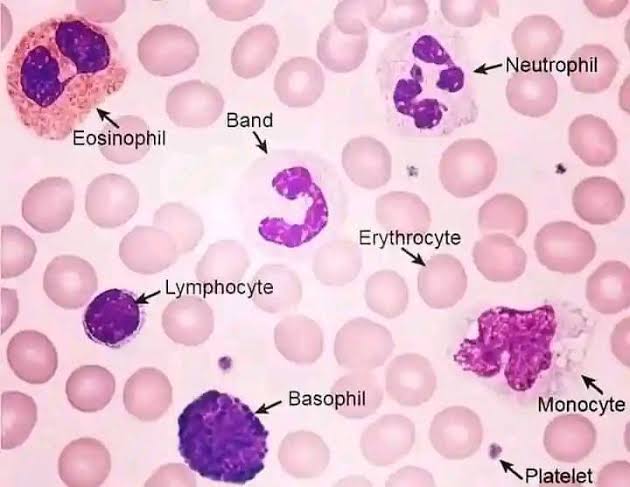
knowt flashcard image

1/7
Looks like no tags are added yet.
Name | Mastery | Learn | Test | Matching | Spaced | Call with Kai |
|---|
No analytics yet
Send a link to your students to track their progress
Resolution
Property of an objective to distinguish the distance between two points as separate and distinct.
Numerical Aperture
A measure of the resolution of an objective. An objective with a 0.15 N.A. permits you to distinguish 15,000 lines per inch. If you view 16,000 lines per inch specimen through a 0.15 N.A. objective, you will never see the lines as separate no matter how powerful the magnification.
Focal length
The distance from the center of the lens to a point where the parallel light rays is brought to a focus. It is a constant of the lens system.
Working Distance
The distance between the front lens of an objective and the surface of the specimen when it is in focus.
Parfocal
The optical and mechanical design where only slight refocusing with the fine focus knob is sufficient to obtain clarity when changing from one lens to another.
Remember!!
Platelet
Erythrocyte
Neutrophil
Concave Mirror
it is used when the source of light (natural or artificial) is of low density.
Plane Mirror
this is used when the source of light is very bright.